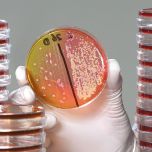
Food Safety, Shelf-life & Chain Control

Food Safety, Shelf-life & Chain Control
Products

Information
A multidisciplinary approach brings safety by design
Consumers are embracing trends such as ‘clean label’, more plant-based diets, and reduced sugar and salt, in order to live and eat healthier. At the same time, there is a need for sustainable food production, for instance by using milder processes. But these changes can open the door to microbes that may impact the safety and quality of your product. Novel ingredients, processes and products may come hand-in-hand with new food safety challenges and risks.
NIZO has expertise throughout the entire chain: from raw materials and ingredients, to formulation and processing, and up to your finished product. We can assess foodborne hazards in your product and your chain, and evaluate the impact of processing and storage conditions on pathogen inactivation, survival and growth. Our food safety and chain control ‘toolbox’ includes quantitative microbial risk assessments, predictive models, high throughput screening platforms, challenge tests and more.
We can also analyse and assess chemical contaminations, such as fungal, bacterial and plant toxins, or chemical residues of pesticides & herbicides, cleaning agents and more. We focus on advanced analysis, and for the routine laboratories we partner with more standardized service providers in our network,
Our insight and expert interpretation of outcomes supports effective root cause analysis and implementation of preventative measures. Using a multidisciplinary approach based on the knowledge of our experts in microbiology, bioinformatics, laboratory, dairy and plant-based food manufacturing, we turn complex results and data into hands-on solutions. So that you can ensure safety and quality are designed in optimally at all levels of the chain.
- Identify and eliminate contaminants
- Design robust products and processes to control contaminants
- Ensuring control in real food & nutrition products
Operations and Services
CertificationConsultingOther Operations & Services
